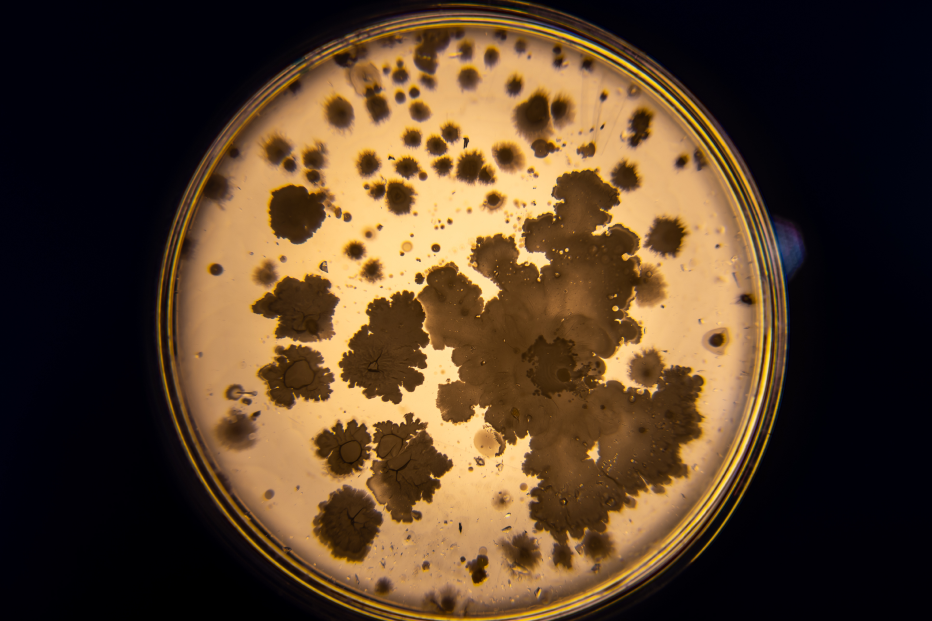

Arte, ciencia y tecnología
Exhibición de proyectos Presente Continuo
Programa de formación y producción
Presente Continuo Org nace de la convicción de que la transformación impulsada por la cuarta revolución tecnológica nos está llevando a un lugar donde los marcos conceptuales y las descripciones heredadas del pasado ya no bastan para entender el presente ni proyectar el futuro.
Nos preguntamos cómo estas transformaciones están cambiando la forma de producir arte y, a la vez, cómo el arte puede ayudarnos a comprender este nuevo mundo en el que vivimos. A partir de estas preguntas, invitamos a los becarios a desarrollar proyectos que exploren posibles respuestas.
proyectos 2025 Fundación Cazadores: Todo ya existe / Latencia / Nunca fuimos individuos / Ermita / Fenomenología de una opacidad / Instrucciones para una obra
Todo ya existe
Fabiana Gallegos, Fernanda Mugica, Facundo Suasnabar, Fabián Urban
El proyecto aborda las nociones de vacío y límite como relatos persistentes que legitimaron procesos de apropiación, colonización y extractivismo. A partir de la forma topográfica de la zanja y de capas contemporáneas —como la minería del carbón o la hidrofractura— se construye un mapa audiovisual especulativo donde se entrelazan pasado, presente y futuros posibles. Estas capas actúan como palimpsestos que revelan tensiones geológicas, históricas y afectivas, proponiendo una lectura expandida del territorio como trama de memorias, conflictos y persistencias.
Latencia
Javier Areal Vélez, Candela Del Valle, Enzo Luciano, Luciana Paoletti
Red de comunicación lateral y no intencional de entidades vivas. Ante las dificultades de consensuar entre humanxs mediante el lenguaje, creamos un nuevo medio de paracomunicación para habilitar intercambios entre microorganismos que habitan nuestros cuerpos. Estas relaciones no son verbales, sino reacciones orgánicas que se vinculan, se transforman y siguen modificándose en el tiempo. Proponemos pensarnos como territorios, seres compuestos, sistemas interespecies que sobreviven por complementariedad.
Nunca fuimos individuos
Penny Di Roma, Matias Jauregui Lorda, Antonella Mecchia, Angel Salazar
Asistimos a un clima turbulento en donde los cambios tecnológicos que asimilamos de manera contínua modifican cómo percibimos tiempo y espacio, acelerando los procesos terrestres y las crisis socioambientales. Esta instalación se propone hacer tangible la velocidad y la escala tecno-industrial a partir de ensayar ritmos alternativos, como las cadenas tróficas presentes en las fermentaciones lentas y las adaptaciones mutuas que pueden verse en los cultivos que desafían las lógicas productivistas. La obra performa conversaciones posibles borroneando las dicotomías aliadas como naturaleza/cultura, cuerpo/mente, individuo/grupo, invitándonos a explorar cómo se modulan los afectos, los sentidos y la política desde una perspectiva en disputa. Confiando en que las prácticas artísticas pueden tomar procedimientos prestados, así como también inventar historias para pensar otros modos de organización de lo común, que no sean ni discrónicos, ni distópicos, sino radicalmente desaceleracionistas.
Ermita
Jorge Crowe, Cecilia Marina Luján, Mecha MIO, Federico Ezequiel Salgado
En toda tecnología existe algo de magia, algo que no podemos ver ni entender, un misterio, algo que desconocemos. Ermita es una invitación a contemplar nuestro vínculo intenso con el celular, agente que media una gran parte de nuestras relaciones con el entorno. Plantea un espacio de recogimiento para desprenderse por un momento del artefacto que se ha transformado en expansión de nuestro cuerpo. Una experiencia audiovisual a partir de las ondas electromagnéticas irradiadas por el celular, capturadas y transformadas en vibraciones sonoras. La pantalla del teléfono se disuelve en pura luz: láser que baja en la capilla como un cuerpo en movimiento. Luz y electromagnetismo en su dualidad entre la materia y lo impalpable, entre lo real y lo abstracto, se vuelven movimiento ascendente. Reflejos de otra dualidad que nos atraviesa: conectarnos/desconectarnos. Este trabajo vuelve tangible aquello que no percibimos sino a través de la tecnología. Como dos estratos de existencia: la que percibimos con nuestros sentidos y otra mediada por la tecnología.
Fenomenología de una opacidad
Laura Colombo, Celeste Massin, Manuel Quaranta, Elias Sarquis
Fenomenología de una opacidad es una instalación escultórica/ performática que interroga lo que pertenece oculto en la materia tecnológica; la energía que persiste tras el colapso y el deseo —humano, arcaico— de volver a acceder a lo que ya no comprendemos. En el espacio, un volumen negro se imporne con su presencia densa y silenciosa. A su alrededor, un conjunto de herramientas rudimentarias -fabricadas con restos electrónicos y metales- sugiere la posibilidad de una acción: romper, intervenir, abrir. Un cuerpo dispuesto se apropia de las herramientas post-tecnológicas, donde la técnica retorna a un estado primitivo. La destrucción de la primera capa expone la imposibilidad de penetrar la segunda y ese gesto físico – simbólico constituye el núcleo del proyecto. La obra dramatiza la lógica de la caja negra, la condición contemporánea de nuestra relación con las tecnologías: el choque con el límite y la constatación de que el deseo se convierte, finalmente, en una poética del fracaso.
Instrucciones para una obra
Paula Bruno Garcén, Oliverio Duhalde, Lihuel González, Ignacio Unrrein
El proyecto investiga y materializa una performance escénica y un audiovisual donde los roles de autoría, dirección e interpretación se ponen en crisis mediante la participación activa de una inteligencia artificial como dramaturga y directora. Propone una escena en la que los cuerpos humanos se ponen al servicio de ideas generadas por una máquina. En lugar de que los artistas utilicen la IA como herramienta, es la propia inteligencia artificial quien diseña el esquema conceptual y escénico de la obra. La pieza audiovisual registra los encuentros con la IA-directora, mientras que los intérpretes en escena ejecutan instrucciones y representan imágenes, escenas y tensiones. La propuesta surge del cruce entre performance y nuevas tecnologías, atendiendo a las preguntas éticas, políticas y estéticas que emergen de esta relación.
proyectos 2024 planta inclán: Argentoratum / BotU / Chuelo / LA LLORONA / RCN_5
Argentoratum
CARPINELLO, RAGESSI, REY, REZZA, STUBRIN
En este proyecto, el paisaje de la costa del Riachuelo ha sufrido un proceso de abstracción, a partir del registro sonoro y visual de su perfil, hasta la producción robótica de una escultura parlante. El objeto artístico apunta a representar los estratos en descomposición que se acumulan con el paso del tiempo y que pueden apreciarse fácilmente desde el agua. El movimiento de la navegación desplaza constantemente el punto de vista y nos desafía a un ejercicio poético de síntesis glocal.
Argentoratum tiene cuerpo y tiene voz. Su canto testimonia el daño profundo, la impotencia y, al mismo tiempo, la resiliencia del vínculo interespecie. También hace referencia a la posibilidad de experimentar lo bello dentro de una precariedad situada y de un sistema económico que fomenta la ruina.
BotU. TAN FANTÁSTICO COMO IMPERFECTO
GATTÁS VARGAS, GELATTI, MANDELBAUM, SARAGÜETA, SENDEROWICZ
La instalación se presenta como un espacio híbrido que combina elementos visuales, escultóricos y performativos. A través de un recorrido físico y conceptual, invitamos a sumergirnos en el universo del sueño. Lo haremos a través de BotU, un dispositivo que desafía los usos convencionales de la inteligencia artificial.
BotU explora las tensiones entre lo onírico y la productividad automatizada, poniendo en cuestión la concepción productivista de la automatización contemporánea al ser entrenado únicamente para soñar.
CHUELO
BUITRÓN, GRAMAJO, MICELI, PICCILLI, RINALDI
Las tecnologías permiten acercarse a mundos microscópicos e interactuar con lo que para la percepción humana es invisible. Pero al mismo tiempo, nos distancian del mundo físico que habitamos -por su carácter blanco, rígido e individualista-, además de ocasionar irremediables daños ambientales y sociales a costa de su avasallante desarrollo.
Una perspectiva no hegemónica y antiextractivista del arte, puede ser pensar que la tecnología del futuro no debería dejar huella en el territorio que habitamos.
Chuelo es una instalación multipantalla realizada a partir de aparatos recuperados. El cuerpo visual, fragmentado e inabarcable, invita a cuestionar la infodemia mediática en
la que la sociedad está sumergida, en la que las múltiples perspectivas sobre lo mismo, lejos de invitar a la reflexión seria y responsable sobre lo que acontece, inquieta y sofoca.
LA LLORONA
FORCADA, GUERSENZVAIG, LOZANO, MONTOYA, MORO CAFIERO
La llorona es un ecosistema zombie de barro, moho, arcilla, plástico, motores y lágrimas que se autoerosiona; un protocyborg que exuda fluidos y lentamente pierde su forma. Su
estructura, realizada con mangueras y alambres, crean un sistema orgánico con órganos, venas y arterias por donde el agua barrosa circula y perfora la superficie creando poros y corroyendo los materiales.
Esta pieza surge de la investigación realizada en la Cuenca Matanza-Riachuelo, una de las
cuencas hídricas más contaminadas de Argentina. Está pensada como una plañidera, que frente a la devastación general, exuda a perpetuidad lágrimas de barro.
RCN_5 UN EXPEDIENTE DE ARQUEOLOGÍA INVERTIDA
ALCON QUINTANILHA, BORISONIK, FRANCONE, SILVA, VALENTE
RCN_5 es una ficción especulativa que se despliega como instalación multimedial y sistémica.Interroga los bordes entre arte, ciencia y política mientras evoca tensiones ecológicas y corporativas en torno al Riachuelo, revelando huellas de tecnologías extractivistas sobre los paisajes y cuerpos. En este episodio, la obra presenta una cápsula bio-maquínica autopoiética llegada desde un futuro incierto, dedicada a documentar la existencia de una empresa que transforma desechos cloacales en biocombustibles. Este organismo híbrido combina bacterias, plantas y códigos algorítmicos con diversas tecnologías, desafiando la discontinuidad entre naturaleza y cultura. En sus flujos energéticos e informacionales, la pieza invita a reflexionar sobre la memoria de los desechos, la ética de lo no humano y el arte como imaginación y arqueología del futuro.